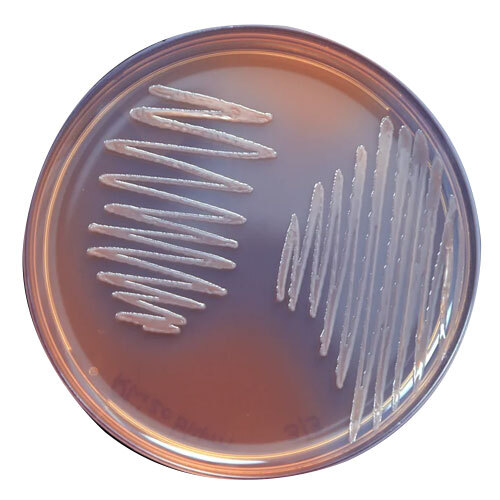
Rhizobium Liquid - Grade: Industrial Grade

Trichoderma Viride - Color: Green
Price:
Get Latest Price
Minimum Order Quantity :
100
In Stock
Product Specifications
| Grade | Agricultural Grade |
| Place of Origin | India |
| Purity(%) | 97% |
| State | Powder |
| Shape | solid |
| Color | Green |
| Moisture (%) | a%0$? 10% |
| Ph Level | 6.5 - 7.5 |
| Supply Ability | 1000 Per Month |
Company Details
ANBR ELIXIR PRIVATE LIMITED, Established in 2007 at Ankleshwar in Gujarat, is a leading Exporter,Manufacturer,Distributor,Supplier,Trading Company of Agro Chemicals in India. ANBR ELIXIR PRIVATE LIMITED is one of Trade India's verified and trusted sellers of listed products. With extensive experience in supplying and trading Trichoderma Viride, ANBR ELIXIR PRIVATE LIMITED has made a reputed name for itself in the market with high-quality Acetobacter Granule, Acetobacter Liquid, All In One, etc.
Focusing on a customer-centric approach, ANBR ELIXIR PRIVATE LIMITED has a pan-India presence and caters to a huge consumer base throughout the country. Buy Agro Chemicals in bulk from ANBR ELIXIR PRIVATE LIMITED at Trade India quality-assured products.
Focusing on a customer-centric approach, ANBR ELIXIR PRIVATE LIMITED has a pan-India presence and caters to a huge consumer base throughout the country. Buy Agro Chemicals in bulk from ANBR ELIXIR PRIVATE LIMITED at Trade India quality-assured products.
Business Type
Exporter, Manufacturer, Distributor, Supplier, Trading Company
Employee Count
25
Establishment
2007
Working Days
Monday To Saturday
GST NO
24AAPCA1856J2ZF
Payment Mode
Others
Related Products
Explore Related Categories
More Product From This seller
Seller Details
GST - 24AAPCA1856J2ZF
Ankleshwar, Gujarat
Marketing Executive
Mrs Dhara Patel
Members since
17 Years
Address
Plot No. 5144, Nr. Prime Industries, Seven Water Tank Road, Paras Chowkdi, GIDC Estate, Ankleshwar, Gujarat, 393002, India
trichoderma viride in Ankleshwar
Report incorrect details